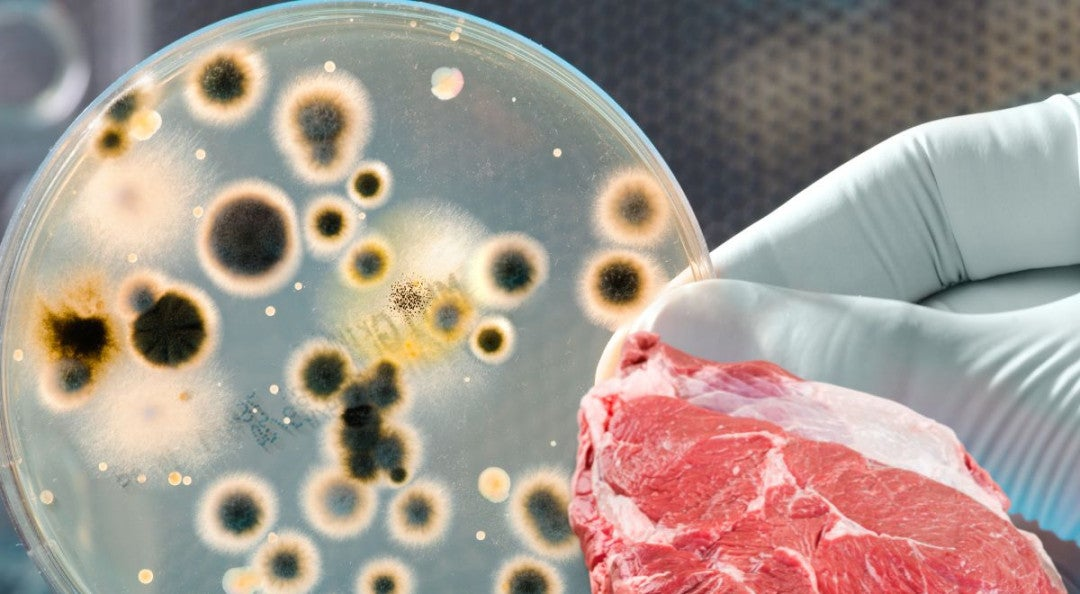

- Sábado, 7 de Febrero, 2026
- Contactos
- Nosotros
- Términos y Condiciones

Últimas Noticias
Santo Domingo. – El Ministerio de Salud Pública informa a la ciudadanía que, en relación con las informaciones que circulan en algunos medios y redes sociales sobre el fallecimiento de una paciente, presuntamente a causa de una bacteria conocida como Flesh Eating Bacteria o "bacteria carnívora", no existe hasta el momento evidencia que confirme esta causa.
Se registró la mañana de este martes el fallecimiento de una femenina de 61 años, en un centro de salud privado, a donde ingresó luego de ser referida desde otro establecimiento de salud por presentar un cuadro de deshidratación aguda secundaria a una gastroenteritis.
De acuerdo con el informe médico inicial, se trató de un cuadro infeccioso abdominal de origen desconocido.
El Ministerio ha solicitado la realización de la autopsia y se encuentra a la espera de la autorización de los familiares, la cual permitirá esclarecer con precisión las causas del deceso.
Hasta el momento, ni el equipo médico tratante ni el equipo técnico del Ministerio de Salud han determinado que se trate de la bacteria mencionada en los rumores.
Según la información preliminar, la señora había acudido junto a otras personas a varios establecimientos de comida y posteriormente presentó síntomas de vómito y diarrea.
Dos personas de ese grupo manifestaron un cuadro de gastroenteritis; sin embargo, no acudieron a ningún centro médico, fueron tratados de manera ambulatoria y presentaron mejoría.
Acciones
El Viceministerio de Gestión de Riesgos, junto a la Dirección General de Medicamentos, Alimentos y Productos Sanitarios (DIGEMAPS), con la participación de las áreas de Salud Ambiental, Epidemiología, Calidad y la Dirección Provincial de Salud correspondiente:
Realizó un levantamiento en los establecimientos visitados por la paciente, se tomaron muestras de superficies y alimentos, las cuales fueron enviadas al Laboratorio de Evaluación de Productos de Consumo Humano de la Digemaps, para su análisis.
Durante el levantamiento, se entrevistó a los responsables de los establecimientos para conocer el proceso de preparación de los alimentos y validar el cumplimiento de los estándares de calidad, asimismo, se verificaron las condiciones de higiene del lugar.
El Ministerio indica, que se han aplicado todos los protocolos correspondientes y que se trabaja de manera coordinada para identificar la causa del cuadro, los resultados de las pruebas serán informados tan pronto estén disponibles.
Además, hace un llamado a la población a mantener la calma y a no esparcir rumores de fuentes no confiables, se recomienda seguir las informaciones oficiales emitidas por esta institución.
